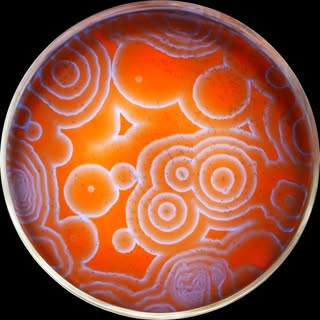
NileRed - Chemistry & Science

Back to Directory
1.1M
Followers
3.0%
Engagement
Why Work with Sbahle Lisakhanya Mzizi🇿🇦
Sbahle Lisakhanya Mzizi is the 2022 Nickelodeon Kids Choice Award winner and a prominent South African influencer celebrated for her vibrant lifestyle content and entrepreneurial spirit. As the CEO of both Sbahle Siakhula and Sbahle Kiddies Treat, she showcases a dedication to both personal well-being and enriching the lives of children. Sbahle's authentic connection with her audience makes her an ideal partner for brands focused on family lifestyle, wellness, and children's products seeking genuine engagement.
View on Instagram

Work with Sbahle Lisakhanya Mzizi🇿🇦
Send a partnership inquiry about this creator
Similar Education Creators on Instagram
Cristãos na Web - Matheus Moraes
1.1M followers
Daniel Alfaro
1.1M followers
NileRed - Chemistry & Science
1.1M followers
Santiago Bilinkis
1.1M followers